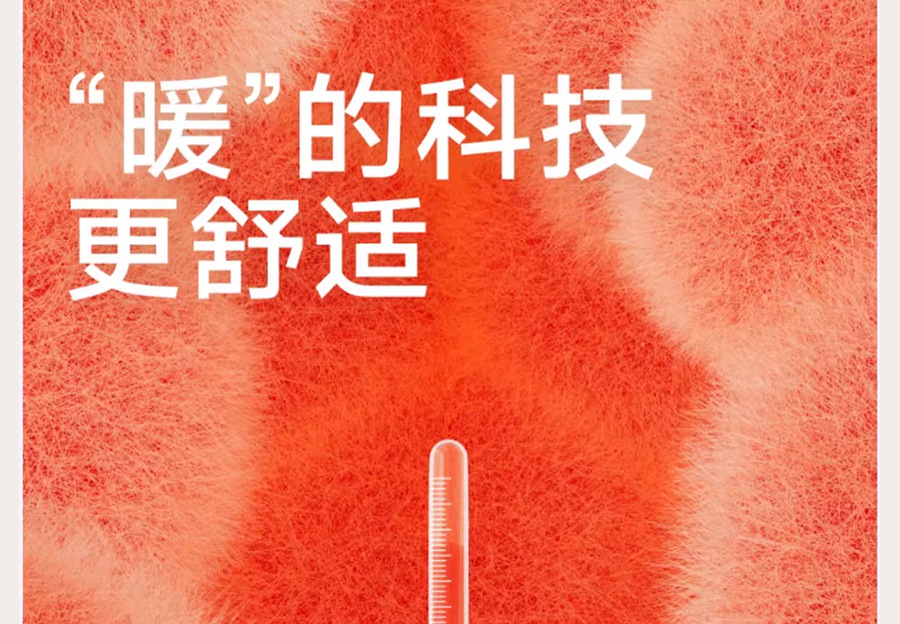

Search history
Clear allSearch by image
XDrag and drop an image here or upload an image
Max 5MB per image
UploadSign In | Join

Search history
Clear allSearch by image
XDrag and drop an image here or upload an image
Max 5MB per image
UploadSign In | Join
X Email Mobile
| size s | ¥59.88 | 75 piece available |
|
| size m | ¥71.88 | 89 piece available |
|
| size l | ¥79.08 | 17 piece available |
|
| size s | ¥59.88 | 107 piece available |
|
| size m | ¥71.88 | 151 piece available |
|
| size l | ¥79.08 | 331 piece available |
|
| size s | ¥59.88 | 74 piece available |
|
| size m | ¥71.88 | 70 piece available |
|
| size l | ¥79.08 | 95 piece available |
|
| size s | ¥59.88 | 115 piece available |
|
| size m | ¥71.88 | 187 piece available |
|
| size l | ¥79.08 | 298 piece available |
|
| size s | ¥59.88 | 80 piece available |
|
| size m | ¥71.88 | 101 piece available |
|
| size l | ¥79.08 | 108 piece available |
|
| size s | ¥59.88 | 74 piece available |
|
| size m | ¥71.88 | 72 piece available |
|
| size l | ¥79.08 | 58 piece available |
|
| size s | ¥59.88 | 101 piece available |
|
| size m | ¥71.88 | 126 piece available |
|
| size l | ¥79.08 | 137 piece available |
|
| size s | ¥59.88 | 76 piece available |
|
| size m | ¥71.88 | 91 piece available |
|
| size l | ¥79.08 | 83 piece available |
|
| size s | ¥116.16 | 60 piece available |
|
| size m | ¥140.16 | 150 piece available |
|
| size l | ¥154.56 | 300 piece available |
|
| size s | ¥116.16 | 76 piece available |
|
| size m | ¥140.16 | 88 piece available |
|
| size l | ¥154.56 | 17 piece available |
|
| size s | ¥116.16 | 75 piece available |
|
| size m | ¥140.16 | 70 piece available |
|
| size l | ¥154.56 | 63 piece available |
|
| size s | ¥116.16 | 83 piece available |
|
| size m | ¥140.16 | 70 piece available |
|
| size l | ¥154.56 | 17 piece available |
|
| size s | ¥116.16 | 43 piece available |
|
| size m | ¥140.16 | 93 piece available |
|
| size l | ¥154.56 | 43 piece available |
|
| size s | ¥116.16 | 74 piece available |
|
| size m | ¥140.16 | 71 piece available |
|
| size l | ¥154.56 | 58 piece available |
|
| size s | ¥116.16 | 77 piece available |
|
| size m | ¥140.16 | 91 piece available |
|
| size l | ¥154.56 | 83 piece available |
|
| size s | ¥116.16 | 43 piece available |
|
| size m | ¥140.16 | 76 piece available |
|
| size l | ¥154.56 | 58 piece available |
|
A new item has been added to your Shopping Cart. You now have items in your Shopping Cart.

Update time:
TOP